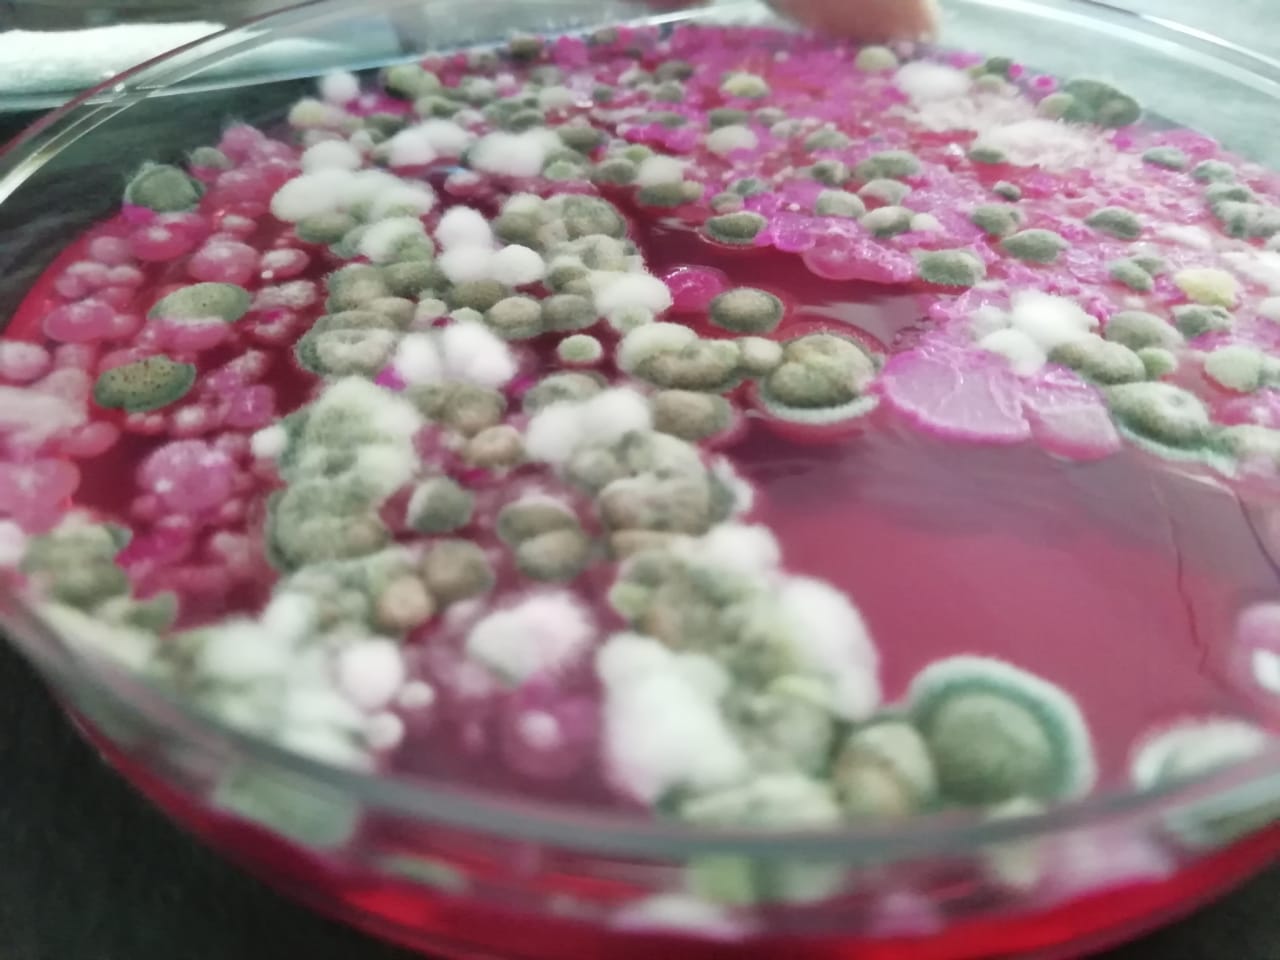

Aflatoxins are one of the most potent and dangerous groups of mycotoxins worldwide. Aflatoxins are produced primarily by the fungi Aspergillus flavus and Aspergillus parasiticus. There are four main types of aflatoxins: B1, B2, G1, and G2. Aflatoxin B1 is the major toxin produced. The clinical effects of aflatoxins may include death, liver cancer, reproductive problems, anemia, immune system suppression, and jaundice. We provide testing and quantification of aflatoxin in seeds, food and consumer products
For testing and analysis get in touch with us:
Contact: Aravind - 9686928701
interface@dextrosetech.com




